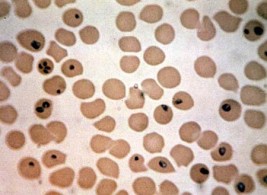
عَدْوى البابيزيا .. عَدُو الخيل – الجزء الأول

استعرض رجل مبتور الساقين، مهاراته في ركوب الخيل، منفذا حركات بهلوانية، وانطلق بالحصان بسرعة عالية دون أن يحدث له مكروه. ويظهر في الفيديو المنشور …
حصان رائع .. حصان سريع .. وثالث وثًاب، وآخر يجمع بين هذه وتلك، ما أجملها وما أبهاها وهي كذلك؛ بدون أمراض ولا آلام. لكن؛ …
تحت رعاية صاحب السمو الشيخ الدكتور سلطان بن محمد القاسمي عضو المجلس الأعلى حاكم الشارقة، ينظم نادي الشارقة للفروسية والسباق «مهرجان الشارقة الدولي السادس …
وافق خادم الحرمين الشريفين الملك سلمان بن عبد العزيز على توليه الرئاسة الفخرية لنادي الفروسية، كما صدر أمره بتولي الأمير متعب بن عبد الله …
شعر ورجز ونثر، وكلام كثير وجميل، قيل في هذه الكائنات. وعنواننا هنا؛ عبارة عن مثل عربي يصور فارسا يخاطب فرسه العربية التي تسمى (زيم) …
قلنا قبلا؛ إن المشاكل السلوكية قد قسمت إلى ثلاث، وقد تحدثنا عن إحداها، وهى المتعلقة بنمط التغذية، والآن؛ سنتعمق فيما تبقى منها، محاولين من …
يعلن مركز الملك عبد العزيز للخيل العربية الأصيلة بديراب عن إقامة دورات تدريبية في مجالات تخصصيه بالخيل العربية ، وذلك بالتعاون بين المركز ومنظمة …